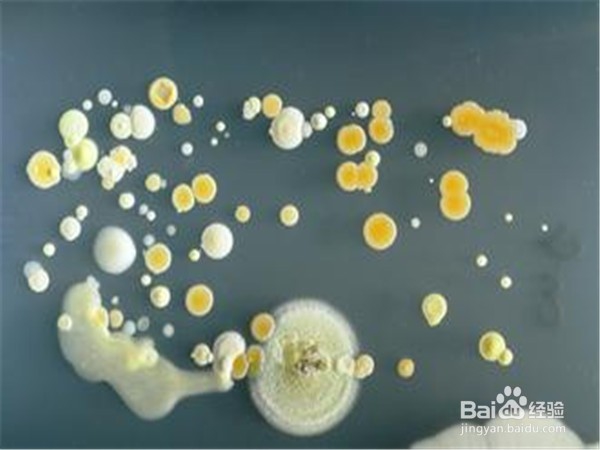

手机对身体的危害
1、手机辐射。尤其是智能机对身体有很大的辐射,打电话的时候辐射强度最大。

2、手机细菌。经研究表明,手机表面存在大量的细菌,我们在吃饭时最好不要玩手机。
3、伤害眼睛。眼睛是心灵的窗口,经常玩手机,会导致视力下降。

4、引发事故。有些人开车时打电话,这是经常出现事故的典型案例。

5、人与人沟通减少。我们每天只和手机打交道,不愿与人沟通,生活失去了原有的精彩。

6、工作效率下降。手机的存在,我们总喜欢查询网络消息,网上聊天,这极大地影响了工作效率。

声明:本网站引用、摘录或转载内容仅供网站访问者交流或参考,不代表本站立场,如存在版权或非法内容,请联系站长删除,联系邮箱:site.kefu@qq.com。
阅读量:51
阅读量:118
阅读量:54
阅读量:59
阅读量:111